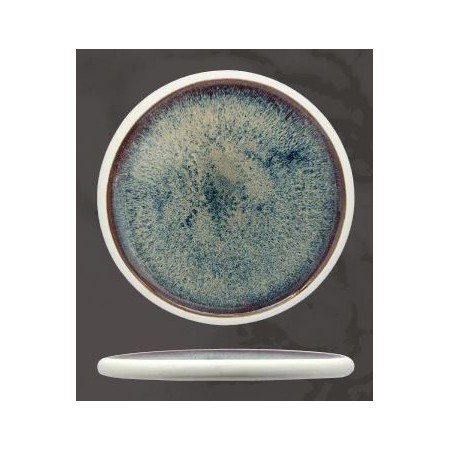
Piatto alto Cm.30 Blu - Genesys

Piatto alto Cm.30 Blu - Genesys

Porcellana bianca satinata blu reactive
L'originalità delle forme, la finitura della porcellana e la particolarità dei co-lori donano un ca-rattere autentico e un look di tendenza all'intera linea.La variazione visiva è la peculiarità di Ge-nesys, ogni pezzo, infatti, è unico, con decori simili ma mai uguale agli altri.
- Nome : Politica di reso di 30 giorni
- Descrizione
Invieremo un articolo sostitutivo (Richiesta di Credito). Ritireremo l'articolo che desideri restituire entro 6 giorni. Confidiamo nella tua comprensione: possiamo accettare resi solo se non sono stati utilizzati o manomessi. È necessario restituire anche la confezione originale e gli accessori insieme all'articolo.
Clicca qui per avere maggiori dettagli